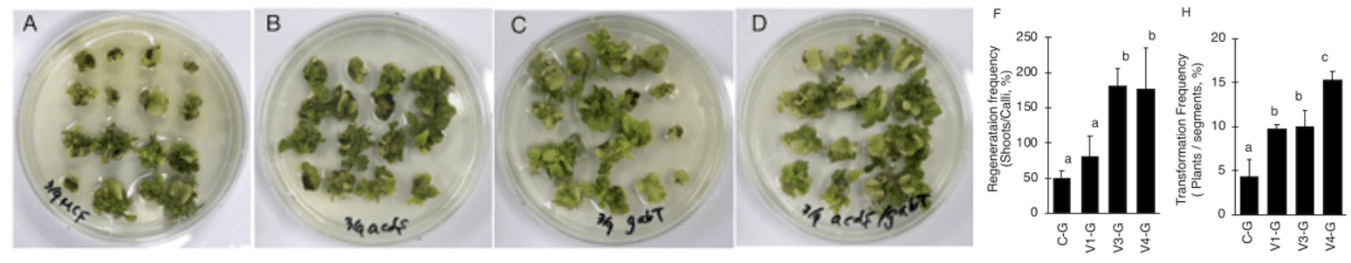

Advantages
・ 従来法に比べて組換え植物の作出効率が向上
・ アグロバクテリウムによる遺伝子導入が困難とされていた植物種でも組換え植物の作出可能になることが期待される
Background and Technology
アグロバクテリウム法は、遺伝子を完全な形で植物に導入できることから、形質転換植物の作製に高頻度に用いられている。
しかし、アグロバクテリウム法による導入効率が低い植物種も多数存在することから遺伝子導入能力を促進したアグロバクテリウムの開発が望まれている。
発明者らは形質転換時に植物体から放出されるGABA(γ-アミノ酪酸)やエチレンが、アグロバクテリウム菌の遺伝子導入に必要なTiプラスミドの複製・伝搬を抑制することで、形質転換効率の低下をもたらしていることを明らかにした。
発明者らはアグロバクテリウム菌にGABAアミノ基転移酵素(GabT)活性、エチレン前駆体であるACC(1-Aminocyclopropane-1-carboxylic acid)分解酵素(AcdS)活性を付与することで、アグロバクテリウム菌による植物への遺伝子導入効率を大きく向上させることができることを見出した。
Data
- 各アグロバクテリウム(A)C-G、(B)V1-G:AcdS+、(C)V3-G:GabT+、(D)V4-G:AcdS+/GabT+を接種したMicro-Tomのカルスから再生したシュート、(F)再生頻度、(H)カルスの再生頻度
- トマト、エリアンサス、トルバム、アシュワガンダについて一過的発現が可能であることを実証済み。
Expectations
多くの植物種における開発を行っている企業、遺伝子組換え作物を開発中の企業、タンパク質高生産分野への展開を考えている企業と、本技術のIn-licenseや形質転換効率の向上をテーマにした共同研究によるコラボレーションを希望している。
Principal Investigator
野中聡子先生、江面浩先生(筑波大学)
Patents and Publications
Satoko Nonaka et. al. Front. Plant Sci., 07 (2019) https://doi.org/10.3389/fpls.2019.01204
Patent No. JP 6300377, US 9944936 (Granted)
Patents and Publications
Publications
- Satoko Nonaka et. al. Front. Plant Sci., 07 (2019) https://doi.org/10.3389/fpls.2019.01204P
Patents
- Patent No. JP 6300377, US 9944936 (Granted)
